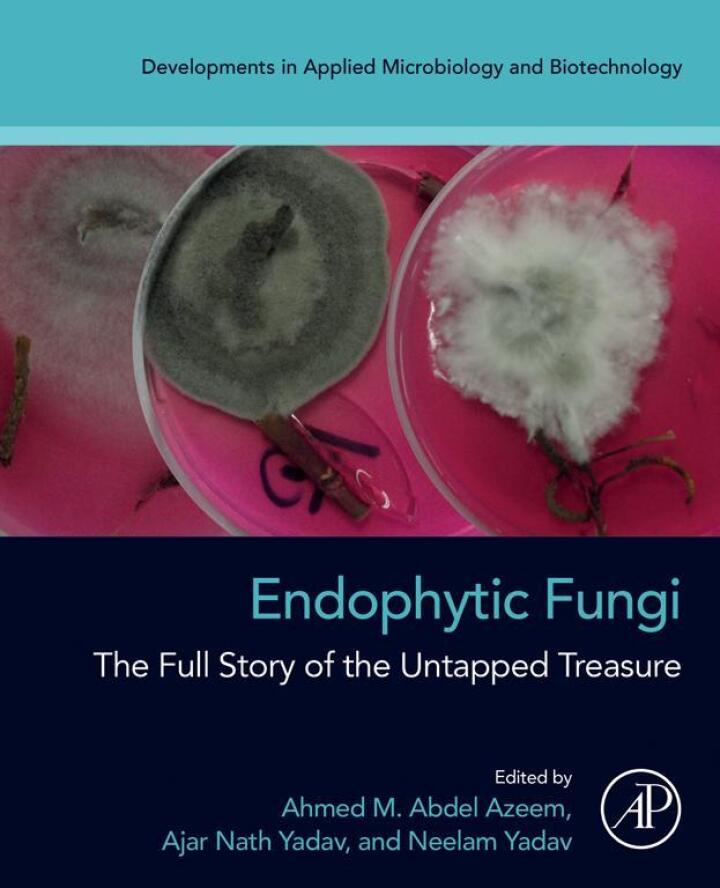

Endophytic Fungi 1st Edition
Grab your attention with a clear pathway into the hidden world of plant microbiomes: Endophytic Fungi, 1st Edition by Ahmed M. Abdel Azeem, Ajar Nath Yadav, and Neelam Yadav is a definitive, accessible guide for scientists, agronomists, students, and industry professionals.
Discover the breadth and depth of endophyte science as this book unpacks the diversity, ecology, and functional roles of fungi that live within plants. Combining foundational theory with contemporary research, it surveys isolation and identification techniques, molecular and bioinformatic approaches, and the ecological dynamics that shape endophytic communities in temperate, tropical, and agricultural landscapes. Readers gain clear insight into how these symbionts influence plant health, stress tolerance, and productivity.
Imagine applying this knowledge to real-world problems: harnessing endophytes for sustainable crop protection, natural product discovery, and improved forestry practices. The authors translate complex topics into practical value—highlighting biocontrol strategies, secondary metabolites with pharmaceutical potential, and experimental design essentials—so you can integrate cutting-edge science into research or field applications.
Whether you’re a researcher mapping plant–microbe interactions, a biotech professional exploring novel bioactives, or an advanced student seeking a rigorous reference, this edition equips you with the tools and perspective to advance your work globally—from South Asia to the Americas and beyond.
Elevate your library with a focused resource on fungal endophytes that blends scholarship and practicality. Order your copy of Endophytic Fungi, 1st Edition today and begin unlocking the ecological and applied potential of plant-associated fungi.